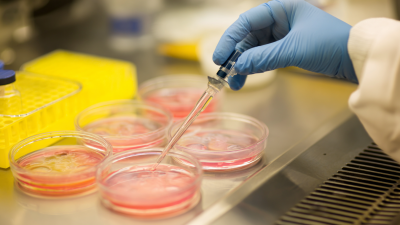
Understanding the Role of Bioreactor Manufacturers in Sustainable Biotechnology

Exploring the Future of Bioreactor Manufacturers: Innovations Shaping Biotechnology in 2024
As the biotech world keeps evolving, the role of bioreactor manufacturers is becoming more and more critical in pushing forward innovations that really shape how pharmaceuticals are made and researched. I mean, a recent market report suggests that the bioreactor market might hit around $6.5 billion by 2024 — crazy, right? This growth is fueled by cool advancements in automation, disposable tech, and even integration with digital platforms. Companies like Shanghai IVEN Pharmatech are right in the thick of things, using their four specialized factories to ramp up production of pharmaceutical equipment and water treatment systems. By adopting the latest tech and refining bioreactor designs, these manufacturers aren’t just keeping up with the rising demand for biopharmaceuticals—they’re also helping make biotech processes more efficient and sustainable. Looking ahead, it’s exciting to think about how these innovations will reshape the industry and, hopefully, lead to better treatments for patients around the world.
Read more »
 By:Ethan - November 15, 2025
By:Ethan - November 15, 2025

How Vial Filling Machines Revolutionize the Pharmaceutical Industry: A Closer Look
In today’s fast-moving pharma world, Vial Filling Machines have really changed the game when it comes to making production more efficient and accurate. If you’ve been following industry trends, you’ll see that the global market for these systems is projected to hit over $5 billion by 2025 — all because there's a rising demand for injectable medicines and biologics. Shanghai IVEN Pharmatech Engineering Co., Ltd. is right at the forefront of this wave. They operate four specialized factories that develop top-notch pharmaceutical machinery, helping streamline the vial filling process. These machines aren’t just about speed; they’re built to meet strict quality standards, boost throughput, and cut down contamination risks. By using cutting-edge tech, they’re helping to keep supply chains running smoothly in a sector where precision and dependability are everything. As the pharma industry keeps evolving, it’s pretty clear that Vial Filling Machines are playing a crucial role in ensuring drugs are delivered safely and effectively — it’s hard to overstate their importance.
Read more »
 By:Ava - November 13, 2025
By:Ava - November 13, 2025

Revolutionizing Diabetes Management with Advanced Injection Pen Assembly Line Technology
Lately, the number of people living with diabetes has really shot up—it's now around 537 million worldwide. That’s a huge jump, and it’s definitely increasing the demand for better, more reliable ways to manage the condition. One of the exciting developments in this space is the Injection Pen Assembly Line, which has completely transformed how insulin pens are made. It’s made the whole process smoother, and honestly, it’s helping improve the quality of diabetes care out there. Shanghai IVEN Pharmatech Engineering Co., Ltd. is right smack in the middle of this innovation. With their deep expertise and four specialized factories, they’re leading the charge by providing top-notch machinery tailored for pharma needs. From recent industry reports, we hear that the global market for insulin delivery devices might hit around $45 billion by 2025—that just shows how crucial advanced manufacturing tech is becoming. By using the latest Injection Pen Assembly Line technology, Shanghai IVEN Pharmatech is really focused on making diabetes management products more efficient and effective. At the end of the day, all of this just means better health outcomes for people everywhere who rely on these devices.
Read more »
 By:Ethan - November 10, 2025
By:Ethan - November 10, 2025

Understanding the Innovations of Blow Fill Seal Technology in Modern Packaging
Lately, Blow Fill Seal (BFS) technology has really been making waves in the packaging world, especially when it comes to pharma stuff. I read somewhere—like in a report from Grand View Research—that by 2027, the global BFS market could hit around USD 4.1 billion. That’s a pretty solid growth rate of about 7.3% annually. The main driver? People are increasingly looking for packaging that’s sterile and free from contamination. Companies like Shanghai IVEN Pharmatech Engineering Co., Ltd. are really pushing the envelope with top-notch machinery for pharmaceutical packaging. Their focus on improving BFS tech lines up perfectly with what the industry needs right now—more efficiency, safer products, and reliable filling and sealing of liquids without messing around with contamination. As companies keep putting patient safety and product quality first, it’s clear that innovations in BFS are gonna stay front and center in modern packaging solutions. It’s pretty exciting, honestly, how much this tech is evolving to meet those demands.
Read more »
 By:Lila - November 8, 2025
By:Lila - November 8, 2025

Understanding the Benefits of Using Prefilled Syringe Filling Machines in Pharmaceutical Production
In the rapidly changing world of pharmaceutical manufacturing, it's hard to overstate how important automation and efficiency really are. Prefilled syringe filling machines are a game-changer—they help smooth out the production process, make sure each dose is spot-on, and boost patient safety. As more and more people prefer prefilled syringes—thanks to their convenience and lower contamination risks—it's become pretty clear that investing in high-tech filling equipment is a smart move for pharma companies. Shanghai IVEN Pharmatech Engineering Co., Ltd. is right there in the thick of it, leading the charge with four top-notch factories dedicated to making advanced medical machinery, including these prefilled syringe fillers. This article’s all about exploring how using these machines can seriously benefit your production—think improved productivity, better accuracy, and just streamlining things overall. By jumping into this cutting-edge tech, companies aren’t just keeping up with industry trends—they’re gaining a competitive edge and setting themselves up for future success.
Read more »
 By:Ethan - November 6, 2025
By:Ethan - November 6, 2025

The Ultimate Guide to Choosing the Right Leak Testing Machine Manufacturers for Your Business Needs
In today’s fast-moving world of manufacturing, choosing the right leak testing machine manufacturer really isn’t something you want to overlook. It’s super important for making sure your products stay up to standard and meet all the industry rules. I’ve been reading some recent reports, and it looks like the global market for leak testing is set to grow quite a bit — mainly because everyone’s really focused on quality and safety these days, especially in areas like pharmaceuticals and food processing. One company that’s worth mentioning is Shanghai IVEN Pharmatech Engineering Co., Ltd. They’ve got four factories that specialize in making equipment for pharma, blood collection tubes, and water treatment. As companies are being scrutinized more and more for their production processes, teaming up with a trustworthy leak test machine supplier is basically a must if you want to avoid risks and keep things running smoothly. By tapping into the latest tech and expertise, manufacturers can meet all the regulatory stuff while still ensuring their products are top-notch and safe for consumers.
Read more »
 By:Lila - November 4, 2025
By:Lila - November 4, 2025

Exploring the Latest Innovations in Vial Filling Equipment for Enhanced Efficiency
In the rapidly changing world of pharma, staying on top of production processes isn’t just important — it’s kind of a must if we want to keep up with all the growing demands for better efficiency and precision. Lately, I’ve come across reports showing that automated vial filling machines have become pretty much essential for speeding things up and cutting down the chance of contamination. The market for these machines is expected to keep growing — like, at a steady 6.5% CAGR — and be worth around 1.5 billion USD by 2027. Speaking of leaders in this space, Shanghai IVEN Pharmatech Engineering Co., Ltd. really knows their stuff. They have four dedicated factories packed with expertise, making all sorts of pharmaceutical machinery — including super advanced vial filling systems designed for different needs. By using the latest tech and innovative designs, IVEN is really pushing to make vial filling more efficient, all while making sure everything stays within tight quality standards and increasing overall production. Pretty exciting stuff, honestly!
Read more »
 By:Ava - November 2, 2025
By:Ava - November 2, 2025

Understanding the Role of Bioreactor Manufacturers in Sustainable Bioprocessing Innovations
So, when it comes to pushing forward sustainable bioprocessing innovations, one thing's pretty clear — bioreactor manufacturers are playing a huge role in shaping what’s next for biotech. Take a company like Shanghai IVEN Pharmatech, for example. They've got top-notch facilities all about pharmaceutical machinery and bioprocessing tools, really showing how important manufacturers are in this constantly changing field. As people start really caring more about eco-friendly production methods, these manufacturers are stepping up, helping develop smarter, greener solutions that make biological processes more efficient. Whether it’s tailoring equipment to specific needs or bringing in the latest tech, they’re not just about cranking out more — they’re also about using resources responsibly. Basically, they’re driving a lot of the innovation in sustainable bioprocessing, and I think that’s pretty exciting to see.
Read more »
 By:Ethan - October 31, 2025
By:Ethan - October 31, 2025

The Future of Pharmaceutical Safety: Revolutionary Aseptic Capping Machines Explained
You know, in the fast-changing world of pharma manufacturing, keeping products safe and intact is more important than ever. That’s why the new Aseptic Capping Machines are such a big deal—they really mark a major step forward. I read somewhere that, according to Grand View Research, the global market for aseptic packaging could hit around USD 415.8 billion by 2027. That's mainly thanks to tighter safety rules and the growing need for contamination-proof processes. Companies like Shanghai IVEN Pharmatech are really leading the charge here, with their four specialized factories focusing on all things pharmaceutical machinery and tech. By adopting these state-of-the-art Aseptic Capping Machines, manufacturers can not only speed things up but also stay within those tough safety standards. Ultimately, it all helps protect patients and makes sure the medicines they take are safe and effective.
Read more »
 By:Ava - October 29, 2025
By:Ava - October 29, 2025
Understanding the Role of Bioreactor Manufacturers in Sustainable Biotechnology
In the fast-changing world of sustainable biotech, the role of Bioreactor Manufacturers has never been more important. As industries scramble to develop greener, more eco-friendly ways of production, companies like Shanghai IVEN Pharmatech are really leading the charge. They've got four specialized factories focusing on everything from pharma machinery to blood collection tubes and water treatment equipment. IVEN is all about coming up with innovative bioreactor solutions that boost efficiency while also cutting down on environmental impact. By blending cutting-edge tech with sustainable practices, these manufacturers are key players in helping the biotech industry become more eco-conscious and sustainable. In this article, I want to explore how Bioreactor Manufacturers are making a real difference—showing how their expertise is crucial for building a more sustainable future for the industry.
Read more »
 By:Ethan - October 27, 2025
By:Ethan - October 27, 2025

Revolutionizing Pharmaceutical Production with Advanced Vial And Ampoule Filling Machine Technology
The pharmaceutical world is going through some pretty exciting changes right now, thanks to new tech—especially when it comes to making injectable meds. If you peek at the latest market reports, you'll see that the global market for vial and ampoule filling machines is expected to grow by more than 8% yearly from 2021 to 2028. That’s mostly because there's a rising need for biologics and sterile products. Shanghai IVEN Pharmatech plays a big part in all this. They’re using some really advanced tech to create high-end filling machines for vials and ampoules. With four dedicated factories focused on pharmaceutical machinery, blood collection tubes, and water treatment setups, they’re pretty well-prepared to meet the demand worldwide. These innovations aren’t just about speeding things up—they also make sure everything is safe and top quality, which ultimately helps improve patient care.
Read more »
 By:Ava - October 25, 2025
By:Ava - October 25, 2025

7 Essential Tips to Choose the Best Leak Testing Machine Manufacturers
In today’s super competitive world of pharmaceutical machinery, choosing the right leak testing machine manufacturer is kinda a big deal. It’s not just about finding something that works — it’s about ensuring your products meet quality standards and comply with industry regulations. According to a report by Research and Markets, the global leak testing market is expected to hit around USD 1.2 billion by 2026. That just shows how much folks are really prioritizing safety and reliability, especially in sectors like pharma and medical devices. Here at Shanghai IVEN Pharmatech Engineering Co., Ltd., we totally get how crucial reliable leak testing is to meet those tough regulatory rules and keep things running smoothly. We’ve got four dedicated factories focused on pharmaceutical machinery, blood collection tube equipment, and water treatment solutions, all aimed at helping our clients stay ahead with innovative and effective products. If you’re trying to pick the right leak testing machine manufacturer, don’t worry — I’ve got some tips to help guide you through the process so you can make the best choice for your business.
Read more »
 By:Ava - October 22, 2025
By:Ava - October 22, 2025

Innovations in Vial Filler Machines at the 138th China Import and Export Fair 2025
You know, in the ever-changing world of pharma manufacturing, the 138th China Import and Export Fair in 2025 is really showcasing some pretty exciting new tech in Vial Filler Machines — stuff that’s so crucial for making sure medicines are safe and effective. Shanghai IVEN Pharmatech Engineering Co., Ltd., a big name when it comes to pharmaceutical machinery, is super proud to show off their latest, cutting-edge tech designed to make vial filling more precise and efficient. They’ve got facilities focused on all sorts of pharma production gear, from blood collection tube machines to water treatment equipment, really keeping them ahead of the game. As the industry keeps evolving, IVEN’s dedicated to providing top-notch solutions that help manufacturers handle the increasing demand for reliable, automated filling systems. All in all, they’re playing a key role in shaping the global pharma scene, and it’s pretty exciting to see where it’s headed.
Read more »
 By:Ethan - October 20, 2025
By:Ethan - October 20, 2025

Exploring Innovation: Liquid Filling Machine Manufacturers at the 138th Canton Fair 2025
As the 138th Canton Fair gets ready to kick off in 2025, everyone's buzzing about how the manufacturing scene is evolving — and a big highlight is the cool new stuff being showcased by Liquid Filling Machine Manufacturers. It’s pretty much the go-to event for industry leaders to show off their latest innovations and tech breakthroughs. One company that really catches the eye is Shanghai IVEN Pharmatech Engineering Co., Ltd. They’ve got a solid lineup of four specialized factories focusing on pharmaceutical machinery, blood collection tube equipment, and water treatment solutions. When you start digging into the opportunities coming out of the Canton Fair, it’s clear that liquid filling machines are playing a huge role in boosting production efficiency and keeping things precise across different sectors. This isn’t just about showing off new gadgets — it’s also about highlighting how dedicated these manufacturers are to quality and innovation, especially in today’s fast-changing marketplace.
Read more »
 By:Ethan - October 18, 2025
By:Ethan - October 18, 2025

How to Select the Perfect Pharma Blister Cartoner Machine for Your Production Needs
Picking the right Pharma Blister Cartoner machine isn’t just a simple choice — it’s a pretty important decision for any pharma company looking to make their production run smoother and more efficient. Here at Shanghai IVEN Pharmatech Engineering Co., Ltd., we totally get how tricky it can be to find that perfect cartoning solution that fits your specific operational needs. We’ve got four dedicated factories doing everything from pharmaceutical machinery and blood tube production to water treatment equipment, so we bring a ton of expertise and innovation to the table. In this guide, I’ll walk you through the key things to think about when choosing a Pharma Blister Cartoner. The goal? Help you boost efficiency, keep your products safe and intact, and make your packaging process a lot more streamlined. Whether you’re ramping things up or just looking to add more automation, understanding these points should help you make smart decisions that line up with your production goals.
Read more »
 By:Ethan - October 16, 2025
By:Ethan - October 16, 2025
Send your message to us:
Write your message here and send it to us


